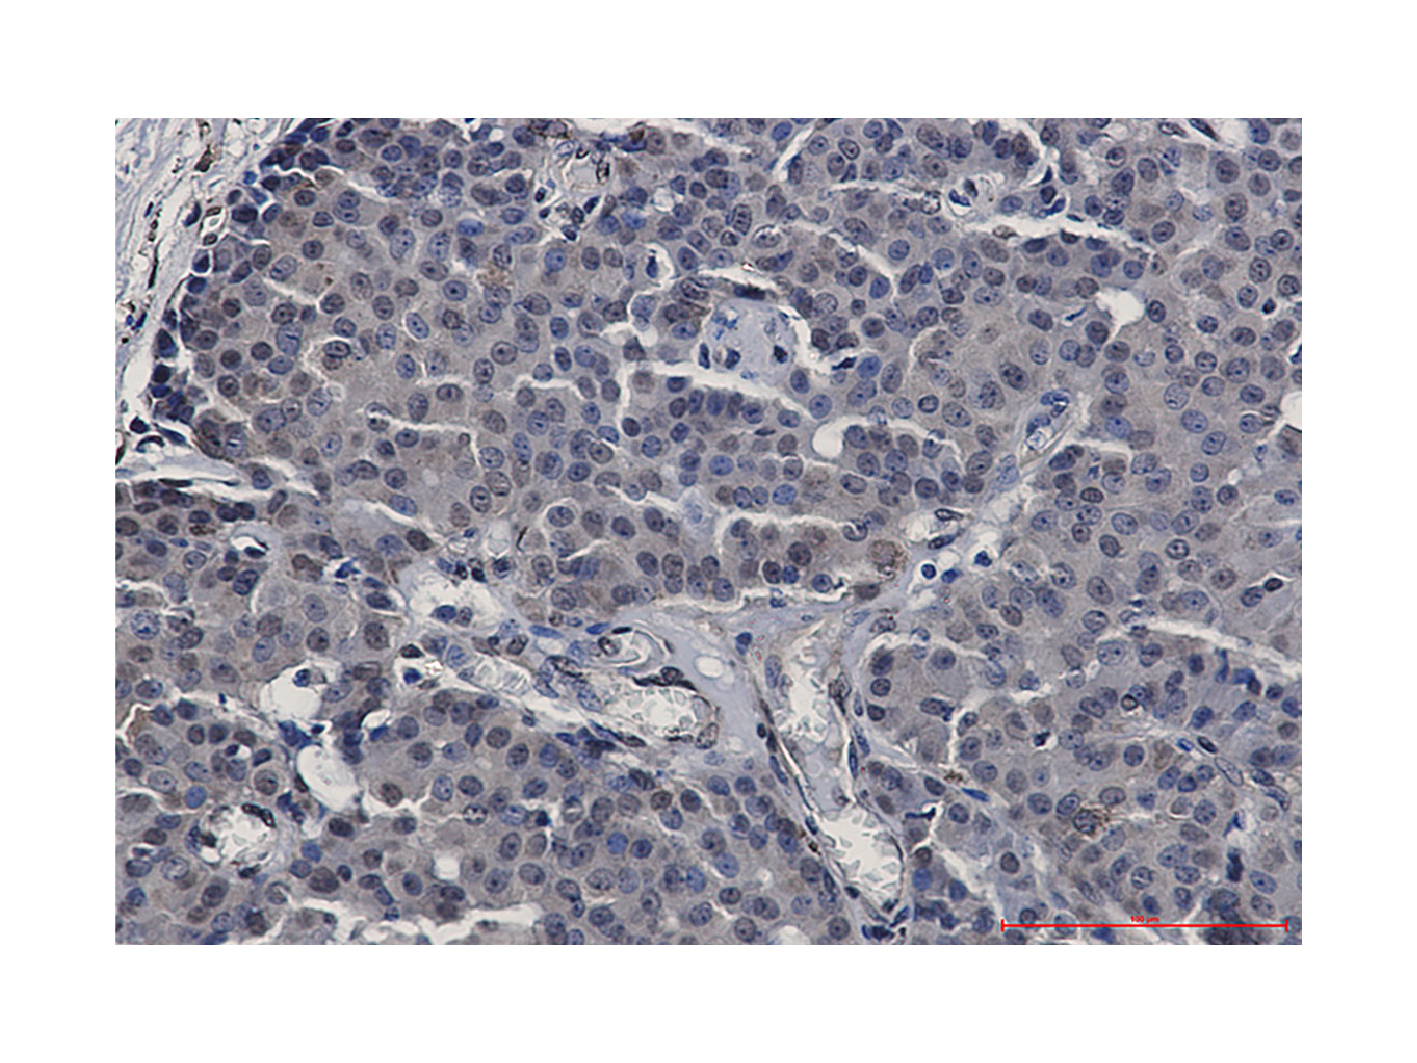

基本信息
产品名称:Recombinant STAT5b Antibody
规格或纯度:ExactAb™, Validated, 重组, 0.5 mg/mL
应用:WB, IF/ICC, IHC
特异性:STAT5b
种属反应性:人(Human), 小鼠(Mouse), 大鼠(Rat)
免疫原:Recombinant protein of human STAT5b (AA 600-786).
阳性对照:WB: HeLa, A549, K562, Raji, Jurkat, Raw264.7, NIH/3T3 and C6 cell lysates. IHC: Human breast cancer tissue. ICC/IF: HeLa cells.
偶联:Unconjugated
产品属性
克隆类型:重组抗体
Format:Whole IgG
亚型:Rabbit IgG
SDS-PAGE:150 kDa
纯化方法:Antigen affinity purified
物理外观:Liquid
储存缓冲液:50mM Tris-Glycine, 150mM NaCl, 40% Glycerol, 0.05% BSA, 0.01% Sodium azide, pH 7.4
防腐剂:0.01% Sodium azide
浓度:0.5 mg/mL
储存温度:-20°C储存,避免反复冻融
运输条件:超低温运输
稳定性与储存:4°C 短期储存(1-2 周)。-20°C下长期保存(24个月)。收货后建议分装。避免冷冻/解冻循环。
功能和特点
宿主种属:兔(Rabbit)
种属反应性:人(Human), 小鼠(Mouse), 大鼠(Rat)
偶联:Unconjugated
图片

>
Western Blot: Recombinant STAT5b Antibody (Ab129471)
Recombinant STAT5b Antibody (Ab129471) - Western Blot
All lanes: Recombinant STAT5b Antibody (Ab129471) at 1/1000 dilution
Samples: Lysates at 20 µg per lane
Secondary: Goat Anti-Rabbit IgG H&L (HRP) (Ab170144) at 1/20000 dilution
Predicted band size: 90 kDa
Observed band size: 87 kDa
Exposure time: 12.2 s

>
IF/ICC: Recombinant STAT5b Antibody (Ab129471)
Recombinant STAT5b Antibody (Ab129471) - IF/ICC
Immunocytochemistry analysis of STAT5b (green) in HeLa cells using Recombinant STAT5b Antibody (Ab129471), and cells were counterstained with DAPI (blue).
>
IHC: Recombinant STAT5b Antibody (Ab129471)
Recombinant STAT5b Antibody (Ab129471) - IHC
Immunohistochemistry analysis of paraffin-embedded Human breast cancer using Recombinant STAT5b Antibody (Ab129471). High-pressure and temperature Sodium Citrate pH 6.0 was used for antigen retrieval.
查看阿拉丁官网此产品相关对应页面:https://www.aladdin-e.com/zh_cn/Ab129471.html



关键字: 信号转导和转录激活因子5b重组兔单克隆抗体 ; 重组STAT5b抗体;Signal transducer and activator of transcription 5B antibody ; STA5B_HUMAN antibody
上海阿拉丁生化科技股份有限公司是A股上市公司((股票代码:688179),专注于科研试剂的研发、生产和销售,已陆续建立多个工厂和研发中心。作为领军企业,阿拉丁始终坚持质量第一,连续13年被评为“最受欢迎试剂品牌”。
阿拉丁目前常备库存试剂产品品种超过7万种,SKU总数超过46万,产品线涵盖了化学试剂、生化试剂、药靶配体、蛋白质和抗体等多个领域,是国内少数化学试剂到生物试剂全面发展的国产试剂品牌,产品同步发布在我们国内外电商平台。